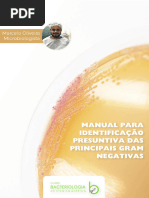

0% acharam este documento útil (0 voto)
36 visualizações3 páginasts-4020752 SS Agar
O Ágar SS é um meio de cultura desidratado utilizado para o isolamento de patógenos entéricos Gram-negativos, especialmente Salmonella, em amostras clínicas. O documento detalha sua composição, método de preparo, características físicas e procedimentos de teste, além de precauções e limitações. É essencial para diagnóstico in vitro e deve ser manuseado por profissionais qualificados em laboratórios.
Enviado por
cenciasbiologicas20212022Direitos autorais
© © All Rights Reserved
Levamos muito a sério os direitos de conteúdo. Se você suspeita que este conteúdo é seu, reivindique-o aqui.
Formatos disponíveis
Baixe no formato PDF, TXT ou leia on-line no Scribd
0% acharam este documento útil (0 voto)
36 visualizações3 páginasts-4020752 SS Agar
O Ágar SS é um meio de cultura desidratado utilizado para o isolamento de patógenos entéricos Gram-negativos, especialmente Salmonella, em amostras clínicas. O documento detalha sua composição, método de preparo, características físicas e procedimentos de teste, além de precauções e limitações. É essencial para diagnóstico in vitro e deve ser manuseado por profissionais qualificados em laboratórios.
Enviado por
cenciasbiologicas20212022Direitos autorais
© © All Rights Reserved
Levamos muito a sério os direitos de conteúdo. Se você suspeita que este conteúdo é seu, reivindique-o aqui.
Formatos disponíveis
Baixe no formato PDF, TXT ou leia on-line no Scribd